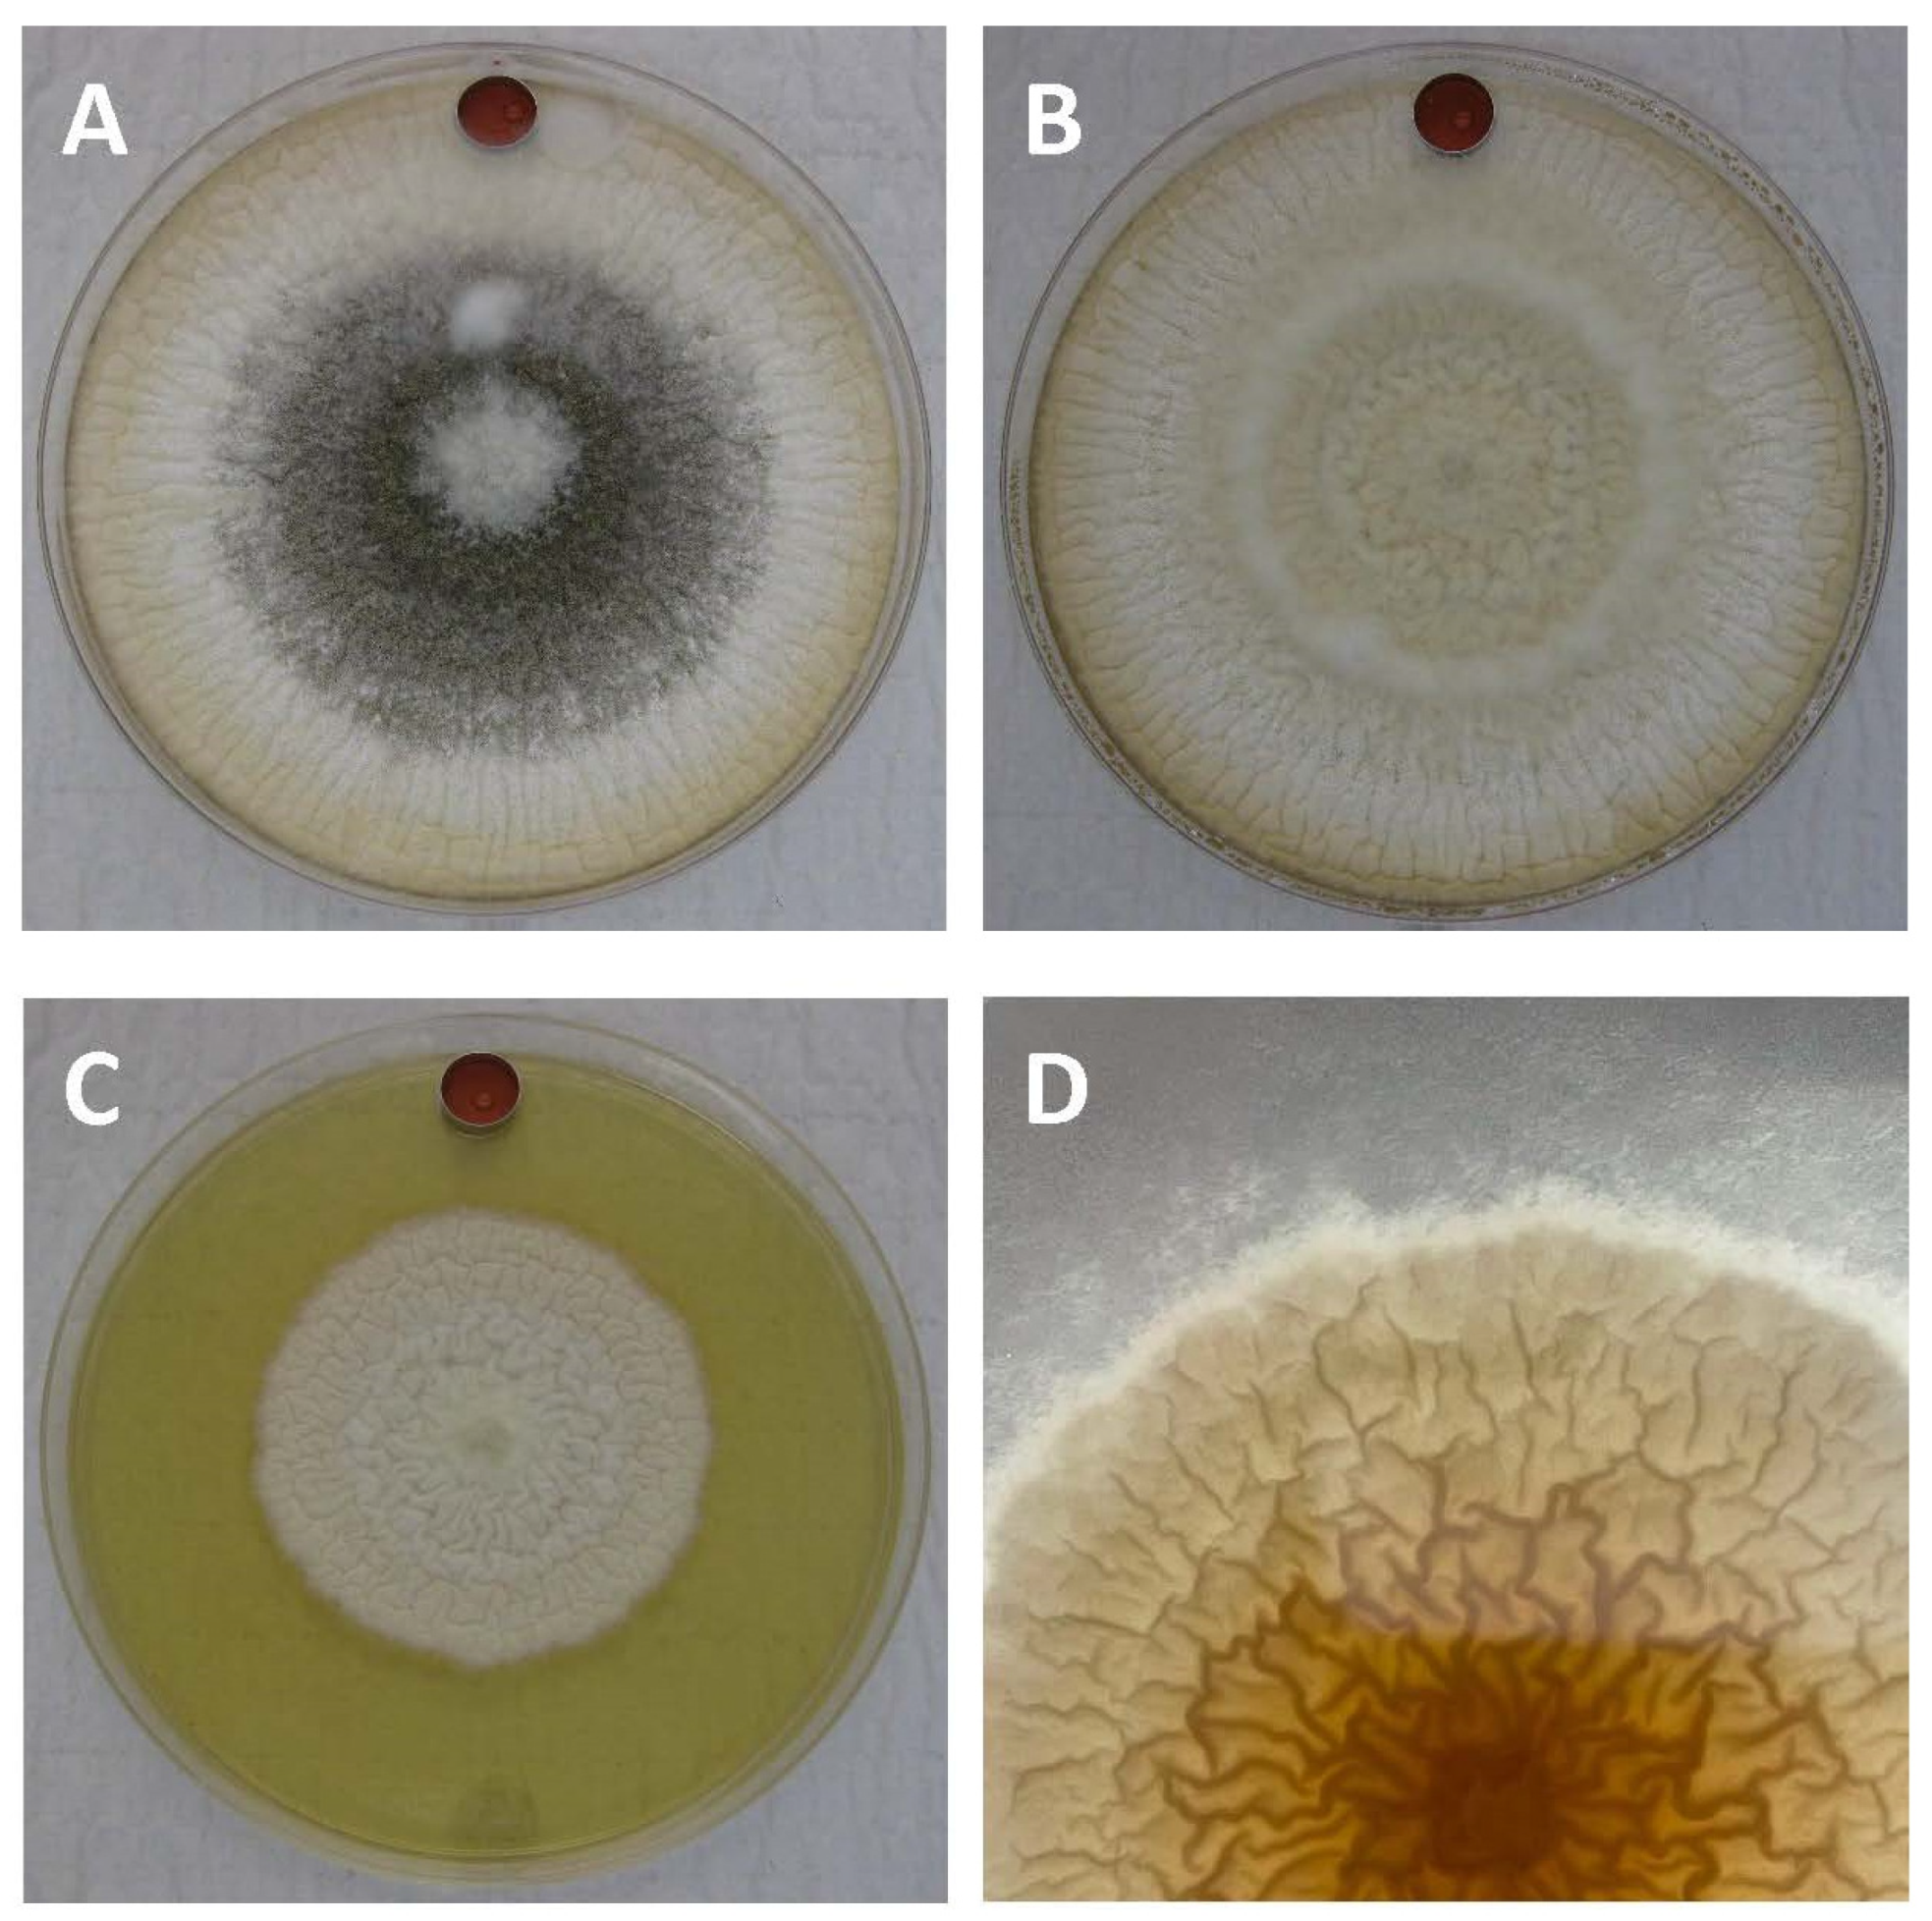
Toxins 14 00340 g001

Cumulative Effects of Non-Aflatoxigenic Aspergillus flavus Volatile Organic Compounds to Abate Toxin Production by Mycotoxigenic Aspergilli
Abstract
:1. Introduction
2. Results
2.1. Impacts of Non-Aflatoxigenic VOC Combinations on Fungal Growth
2.2. Assessment of Toxic Secondary Metabolite Production in LA1–LA4 Control Cultures
2.3. Impact of Non-Aflatoxigenic VOC Combinations on LA1 Mycotoxin Production
2.4. Impact of Non-Aflatoxigenic VOC Combinations on LA2 Mycotoxin Production
2.5. Impact of Non-Aflatoxigenic VOC Combinations on LA3 Mycotoxin Production
2.6. Impact of Non-Aflatoxigenic VOC Combinations on LA4 Mycotoxin Production
3. Discussion
4. Conclusions
5. Materials and Methods
5.1. Louisiana Strains Used in VOC Study
5.2. Experimental Protocol for VOC Study
5.3. Mycotoxin Analysis
5.4. Handling of Data
Supplementary Materials
Author Contributions
Funding
Institutional Review Board Statement
Informed Consent Statement
Acknowledgments
Conflicts of Interest
References
- Gbashi, S.; Madala, N.E.; De Saeger, S.; De Boevre, M.; Adekoya, I.; Adebo, O.A.; Njobeh, P.B. The socio-economic impact of mycotoxin contamination in Africa. In Mycotoxins—Impact and Management Strategies, 1st ed.; Njobeh, P.B., Stepman, F., Eds.; IntechOpen: London, UK, 2018. [Google Scholar] [CrossRef] [Green Version]
- Kimanya, M.E.; Routledge, M.N.; Mpolya, E.; Ezekiel, C.N.; Shirima, C.P.; Gong, Y.Y. Estimating the risk of aflatoxin-induced liver cancer in Tanzania based on biomarker data. PLoS ONE 2021, 16, e0247281. [Google Scholar] [CrossRef] [PubMed]
- Shahba, S.; Mehrzad, J.; Malvandi, A.M. Neuroimmune disruptions from naturally occurring levels of mycotoxins. Environ. Sci. Pollut. Res. 2021, 28, 32156–32176. [Google Scholar] [CrossRef] [PubMed]
- Medina, Á.; Rodríguez, A.; Magan, N. Climate change and mycotoxigenic fungi: Impacts on mycotoxin production. Curr. Opin. Food Sci. 2015, 5, 99–104. [Google Scholar] [CrossRef]
- Abd El-Aziz, A.R.M.; Shehata, S.M.; Hisham, S.M.; Alobathani, A.A. Molecular profile of aflatoxigenic and non-aflatoxigenic isolates of Aspergillus flavus isolated from stored maize. Saudi J. Biol. Sci. 2021, 28, 1383–1391. [Google Scholar] [CrossRef] [PubMed]
- Perrone, G.; Gallo, A.; Logrieco, A.F. Biodiversity of Aspergillus section Flavi in Europe in relation to the management of aflatoxin risk. Front. Microbiol. 2014, 5, e377. [Google Scholar] [CrossRef] [PubMed] [Green Version]
- Rajasekaran, K.; Cary, J.W.; Cleveland, T.E. Prevention of preharvest aflatoxin contamination through genetic engineering of crops. Mycotoxin Res. 2006, 22, 118–124. [Google Scholar] [CrossRef] [PubMed]
- Abbas, H.K.; Zablotowicz, R.M.; Horn, B.W.; Phillips, N.A.; Johnson, B.J.; Jin, X.; Abel, C.A. Comparison of major biocontrol strains of non-aflatoxigenic Aspergillus flavus for the reduction of aflatoxins and cyclopiazonic acid in maize. Food Addit. Contam. A 2011, 28, 198–208. [Google Scholar] [CrossRef]
- Mauro, A.; Garcia-Cela, E.; Pietri, A.; Cotty, P.J.; Battilani, P. Biological control products for aflatoxin prevention in Italy: Commercial field evaluation of atoxigenic Aspergillus flavus active ingredients. Toxins 2018, 10, 30. [Google Scholar] [CrossRef] [Green Version]
- Bandyopadhyay, R.; Ortega-Beltran, A.; Akande, A.; Mutegi, C.; Atehnkeng, J.; Kaptoge, L.; Senghor, A.; Adhikari, B.; Cotty, P. Biological control of aflatoxins in Africa: Current status and potential challenges in the face of climate change. World Mycotoxin J. 2016, 9, 771–789. [Google Scholar] [CrossRef] [Green Version]
- Kinyungu, S.; Isakeit, T.; Ojiambo, P.S.; Woloshuk, C.P. Spread of Aspergillus flavus and aflatoxin accumulation in postharvested maize treated with biocontrol products. J. Stored Prod. Res. 2019, 84, e101519. [Google Scholar] [CrossRef]
- Cotty, P.J.; Antilla, L.; Wakelyn, P.J.; Vincent, C.; Goettel, M.S.; Lazarovits, G. Competitive exclusion of aflatoxin producers: Farmer-driven research and development. In Biological Control: A Global Perspective, 1st ed.; CABI International: Wallingford, UK, 2007; pp. 241–253. [Google Scholar]
- Mehl, H.L.; Cotty, P.J. Nutrient environments influence competition among Aspergillus flavus genotypes. Appl. Environ. Microbiol. 2013, 79, 1473–1480. [Google Scholar] [CrossRef] [PubMed] [Green Version]
- Huang, C.; Jha, A.; Sweany, R.; DeRobertis, C.; Damann, K.E., Jr. Intraspecific aflatoxin inhibition in Aspergillus flavus is thigmoregulated, independent of vegetative compatibility group and is strain dependent. PLoS ONE 2011, 6, e23470. [Google Scholar] [CrossRef] [PubMed]
- Moore, G.G.; Lebar, M.D.; Carter-Wientjes, C.H. The role of extrolites secreted by nonaflatoxigenic Aspergillus flavus in biocontrol efficacy. J. Appl. Microbiol. 2018, 126, 1257–1264. [Google Scholar] [CrossRef] [PubMed]
- Moore, G.G.; Lebar, M.D.; Carter-Wientjes, C.H.; Gilbert, M.K. The potential role of fungal volatile organic compounds in Aspergillus flavus biocontrol efficacy. Biol. Control 2021, 160, 104686. [Google Scholar] [CrossRef]
- Coppock, R.W.; Dziwenka, M.M. Chapter 32—Mycotoxins. In Biomarkers in Toxicology, 1st ed.; Gupta, R.C., Ed.; Academic Press: Cambridge, MA, USA, 2014; pp. 549–562. [Google Scholar] [CrossRef]
- Gallagher, R.T.; Wilson, B.J. Aflatrem, the tremorgenic mycotoxin from Aspergillus flavus. Mycopathologia 1979, 66, 183–185. [Google Scholar] [CrossRef]
- Valdes, J.J.; Cameron, J.E.; Cole, R.J. Aflatrem: A tremorgenic mycotoxin with acute neurotoxic effects. Environ. Health Perspect. 1985, 62, 459–463. [Google Scholar] [CrossRef]
- TePaske, M.R.; Gloer, J.B.; Wicklow, D.T.; Dowd, P.F. Aflavazole: A new antiinsectan carbazole metabolite from the sclerotia of Aspergillus flavus. J. Org. Chem. 1990, 55, 5299–5301. [Google Scholar] [CrossRef]
- Gloer, J.B.; TePaske, M.R.; Sima, J.S.; Wicklow, D.T.; Dowd, P.F. Antiinsectan aflavinine derivatives from the sclerotia of Aspergillus flavus. J. Org. Chem. 1988, 53, 5457–5460. [Google Scholar] [CrossRef]
- Okoth, S.; De Boevre, M.; Vidal, A.; Diana Di Mavungu, J.; Landschoot, S.; Kyallo, M.; Njuguna, J.; Harvey, J.; De Saeger, S. Genetic and toxigenic variability within Aspergillus flavus population isolated from maize in two diverse environments in Kenya. Front. Microbiol. 2018, 9, e57. [Google Scholar] [CrossRef]
- Lyu, A.; Yang, L.; Wu, M.; Zhang, J.; Li, G. High efficacy of the volatile organic compounds of Streptomyces yanglinensis 3–10 in suppression of Aspergillus contamination on peanut kernels. Front. Microbiol. 2020, 11, 142. [Google Scholar] [CrossRef]
- Tejero, P.; Martín, A.; Rodríguez, A.; Galván, A.I.; Ruiz-Moyano, S.; Hernández, A. In vitro biological control of Aspergillus flavus by Hanseniaspora opuntiae L479 and Hanseniaspora uvarum L793, producers of antifungal volatile organic compounds. Toxins 2021, 13, 663. [Google Scholar] [CrossRef] [PubMed]
- Jaibangyang, S.; Nasanit, R.; Limtong, S. Biological control of aflatoxin-producing Aspergillus flavus by volatile organic compound-producing antagonistic yeasts. BioControl 2020, 65, 377–386. [Google Scholar] [CrossRef]
- Institute of Food Science and Technology Information Report—Mycotoxins. Available online: https://www.ifst.org/resources/information-statements/mycotoxins (accessed on 23 August 2021).
- Gloer, J.B. Antiinsectan natural products from fungal sclerotia. ACC Chem. Res. 1995, 28, 342–350. [Google Scholar] [CrossRef]
- Moore, G.G. Practical considerations will ensure the continued success of pre-harvest biocontrol using non-aflatoxigenic Aspergillus flavus strains. Crit. Rev. Food Sci. Nutr. 2021, 62, 4208–4225. [Google Scholar] [CrossRef]
- Burdock, G.A.; Flamm, W.G. Review article: Safety assessment of the mycotoxin cyclopiazonic acid. Int. J. Toxicol. 2000, 19, 195–218. [Google Scholar] [CrossRef]
- Bennett, J.W.; Inamdar, A.A. Are some fungal volatile organic compounds (VOCs) mycotoxins? Toxins 2015, 7, 3785–3804. [Google Scholar] [CrossRef] [Green Version]
- Sweany, R.R.; Damann, K.E., Jr.; Kaller, M.D. Comparison of soil and corn kernel Aspergillus flavus populations: Evidence for niche specialization. Phytopathology 2011, 101, 952–959. [Google Scholar] [CrossRef] [Green Version]

| Strain | AFB1 (ppb) | AFB2 (ppb) | AFG1 (ppb) | AFG2 (ppb) | CPA (ppm) | Total IDTs (ppb) |
|---|---|---|---|---|---|---|
| LA1 | 0 | 0 | 0 | 0 | 0 | 81,538 (7785) |
| LA2 | 20,975 (3183) | 163 (20) | 0 | 0 | 1202 (180) | 280 (164) |
| LA3 | 54,084 (5384) | 492 (33) | 0 | 0 | 16,651 (32) | 65,757 (32,632) |
| LA4 | 164,413 (7179) | 3471 (800) | 109,084 (13,413) | 2062 (316) | 5157 (400) | 605 (351) |
Publisher’s Note: MDPI stays neutral with regard to jurisdictional claims in published maps and institutional affiliations. |
© 2022 by the authors. Licensee MDPI, Basel, Switzerland. This article is an open access article distributed under the terms and conditions of the Creative Commons Attribution (CC BY) license (https://creativecommons.org/licenses/by/4.0/).
Share and Cite
Moore, G.G.; Lebar, M.D.; Carter-Wientjes, C.H. Cumulative Effects of Non-Aflatoxigenic Aspergillus flavus Volatile Organic Compounds to Abate Toxin Production by Mycotoxigenic Aspergilli. Toxins 2022, 14, 340. https://doi.org/10.3390/toxins14050340
Moore GG, Lebar MD, Carter-Wientjes CH. Cumulative Effects of Non-Aflatoxigenic Aspergillus flavus Volatile Organic Compounds to Abate Toxin Production by Mycotoxigenic Aspergilli. Toxins. 2022; 14(5):340. https://doi.org/10.3390/toxins14050340
Chicago/Turabian StyleMoore, Geromy G., Matthew D. Lebar, and Carol H. Carter-Wientjes. 2022. "Cumulative Effects of Non-Aflatoxigenic Aspergillus flavus Volatile Organic Compounds to Abate Toxin Production by Mycotoxigenic Aspergilli" Toxins 14, no. 5: 340. https://doi.org/10.3390/toxins14050340
APA StyleMoore, G. G., Lebar, M. D., & Carter-Wientjes, C. H. (2022). Cumulative Effects of Non-Aflatoxigenic Aspergillus flavus Volatile Organic Compounds to Abate Toxin Production by Mycotoxigenic Aspergilli. Toxins, 14(5), 340. https://doi.org/10.3390/toxins14050340

